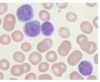

Origine du lymphocyte B
not that deep
Bourse de fabricius (oiseau)
d’ou le nom lymphocyte B
% des lymphocytes B parmis les lymphocytes sanguin
5-15%
Quels sont les marqueurs spécifiques des lymphocytes B
Cytometrie en flux
CD19
CD20
CD21
Rôle des lymphocytes B
immunité humorale via la fabrication d’immunoglobuline spécifiques
Quels sont les 2 organes de developpement du lymphocyte B? Quelle est la fonction principale de chacun des lieux?
1. Moelle osseuse
production d’Ig de surface
2. Système lymphatique
monter l’immunité humorale

Où trouve-t-on le lymphocyte B mature mais naif?
Dans la moelle osseuse
Il se rend au système lymphatique pour être activé par un antigene

Dans la moelle osseuse, le développement du LB est antigène dépendant ou indépendant?
Indépendant
Le lymphocyte se différencie à partir de la cellule souche lymphoïde. Il reach un stade mature mais il n’a pas encore été exposé à un antigen.
Quel est l’ordre de différentiation des LB
6 stades
- Cellule souche lymphoïde
- Cellule Pro-B
- Cellule Pré-B
- Cellule B immature
- Cellule B mature
- Cellule B activée
Sur quels types de lymphocyte B peut on retrouver l’antigen CD34?
(2x) IMPORTANT !!!!
Cellule souche
Cellule pro-b

Donc cest vrm un marqueur de cellules blastique (potentiellement marqueur de leucemie/lymphome)
Les antigens CD19 et CD20 se trouvent sur quels types de LB ?
(5x Pas par coeur
Dès le stade Pro-B donc
Pro-B
Pré-B
Cellule B immature
Cellule B mature
Cellule B activé

L’antigen CD21 se trouve sur quels types de LB ?
(4x) Pas pas coeur
Dès le stade Pré-b donc:
Pré-b
Cellule B immature
Cellule B mature
Cellule B activée

Chez quel type de lymphocyte B on peut retrouver le CD23
3x Pas par coeur
Cellule B immature
Cellule B mature
Cellule B activée

Liste des organes lymphoïdes primaires et secondaires
Moelle
Thymus
Rate
Ganglion
Tissu lymphoïde pulmonaire et digestif
Où se trouve le précurseur le plus immature du lymphocyte T
Moelle osseuse
où a lieu la maturation du lymphocyte T
dans le thymus
Qu’acquièrent les LT durant leur maturation thymique?
- Des antigènes de surfaces spécifiques (CD2-CD3-CD7)
- Des récepteurs (TCR 1et TCR 2)
2 types de LT mature
LT CD4
LT CD8
un ptit rappel
LT CD4: intéragissent avec CMHII
LT CD8: intéragissent avec CMHI et NK
Ou se trouve le thymus
Le médiastin antérieur: sous la thyroïde et au-dessus du coeur

Décrire anatomiquement le thymus

Organe plat et bilobé
Au niveau microscopique :
- Une capsule
- Des trabécule
- Des lobules (cortex et médulla)
vrai ou faux, la taille du thymus augmente avec l’âge
faux elle diminue avec l’âge au point de devenir presqu’absente chez l’adulte
Où se situe la rate
hypochondre gauche
5 rôles de la rate
- sénescence des GR
- réponse immunitaire
- élimination des bactéries dans le sang
(Particulièrement parce qu’elle opsonise des bactéries encapsulées: H. influenzae, pneumocoque, meningocoque) - réservoir cellulaire
- hématopoiétèse extra-médullaire
nommes 5 causes de splénomégalie
- vasculaire-congestive
- infection
- néoplasique
4.inflammatoire - infiltrative (par des cellules non néoplasiques)
Hyposplenisme vs. hypersplenisme
Hypo: baisse d’activité de la rate
Hyper: suractivation de la rate